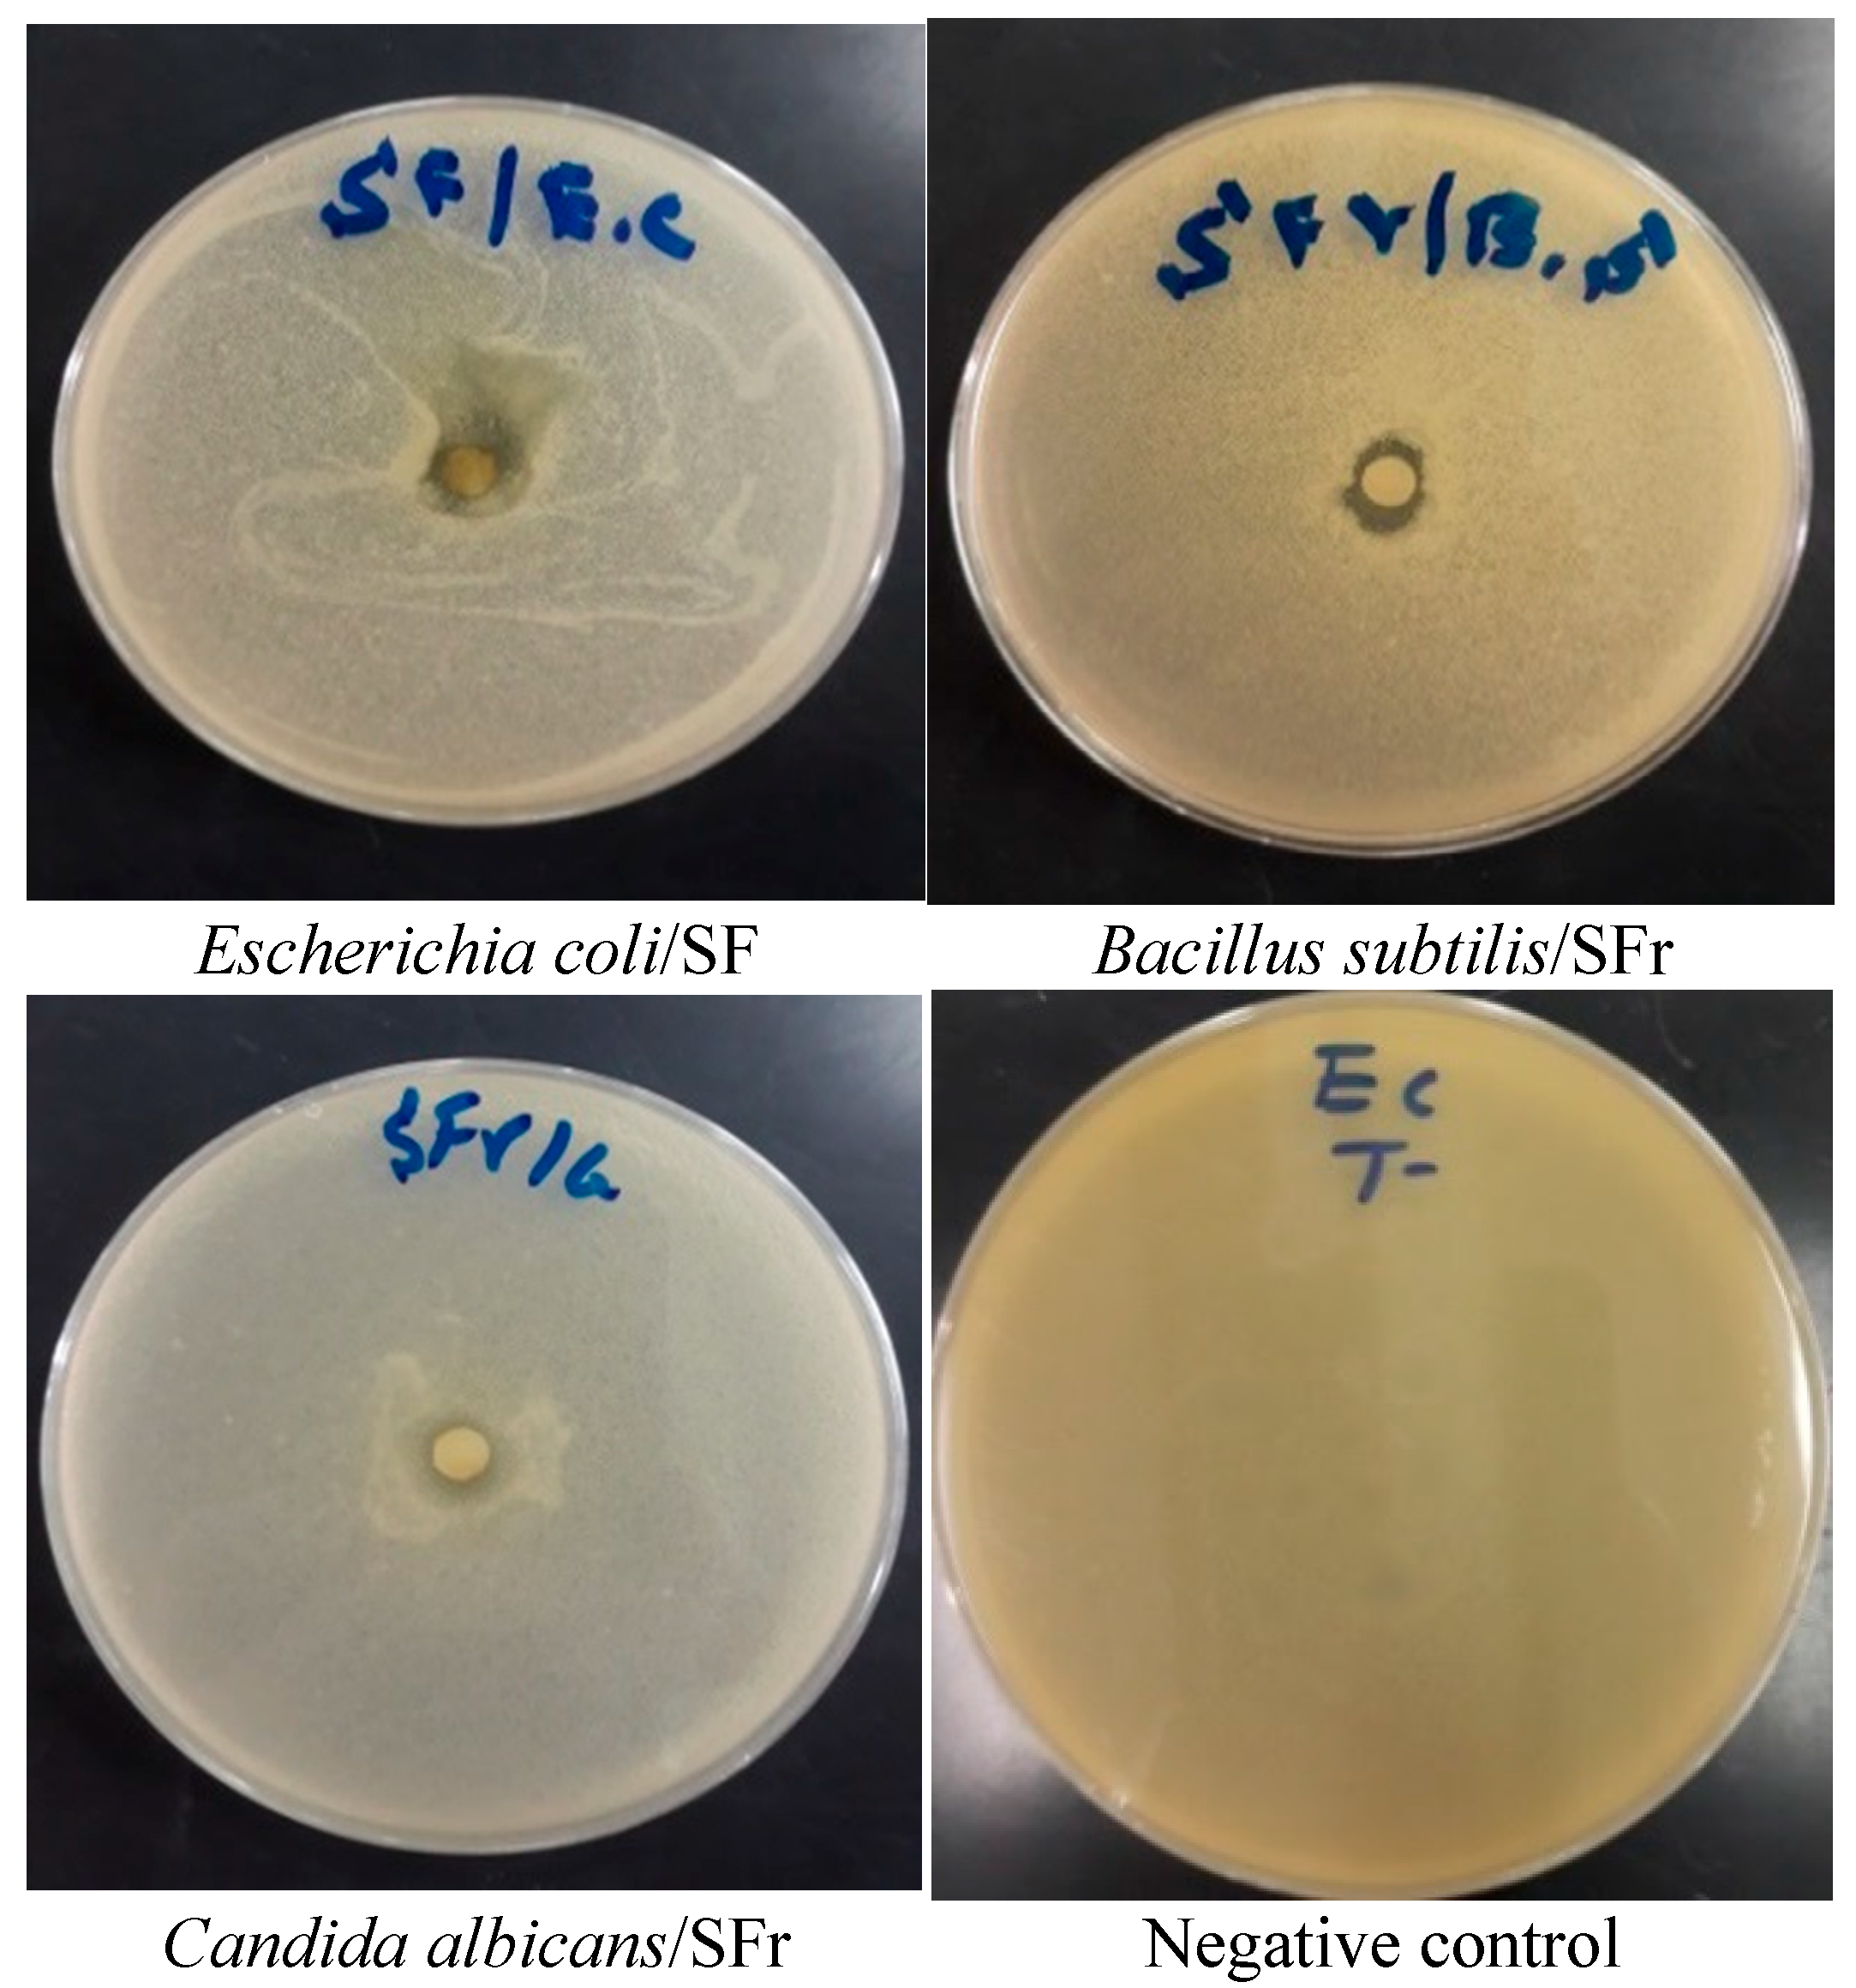
Molecules 27 08688 g004 Molecules 27 08688 g004

Abstract
The present work was designed to study the chemical composition and the antioxidant and antimicrobial properties of fruits (SFr) and leaf (SF) extracts from Solanum elaeagnifolium var. obtusifolium (Dunal) Dunal (S. elaeagnifolium). The chemical composition was determined using HPLC-DAD analysis. Colorimetric methods were used to determine polyphenols and flavonoids. Antioxidant capacity was assessed with DPPH, TAC, and FRAP assays. Antimicrobial activity was assessed using disk diffusion and microdilution assays against two Gram (+) bacteria (Staphylococcus aureus ATCC-6633 and Bacillus subtilis DSM-6333) and two Gram (-) bacteria (Escherichia coli K-12 and Proteus mirabilis ATCC-29906), while the antifungal effect was tested vs. Candida albicans ATCC-1023. By use of in silico studies, the antioxidant and antimicrobial properties of the studied extracts were also investigated. HPLC analysis showed that both fruits and leaf extracts from S. elaeagnifolium were rich in luteolin, quercetin, gallic acid, and naringenin. Both SFr and SF generated good antioxidant activity, with IC50 values of 35.15 ± 6.09 μg/mL and 132.46 ± 11.73 μg/mL, respectively. The EC50 of SFr and SF was 35.15 ± 6.09 μg/mL and 132.46 ± 11.73 μg/mL, respectively. SFr and SF also showed a good total antioxidant capacity of 939.66 ± 5.01 μg AAE/and 890.1 ± 7.76 μg AAE/g, respectively. SFr had important antibacterial activity vs. all tested strains—most notably B. subtilis DSM-6333 and E. coli, with MICs values of 2.5 ± 0.00 mg/mL and 2.50 ± 0.00 mg/mL, respectively. SFr demonstrated potent antifungal activity against C. albicans, with an inhibition diameter of 9.00 ± 0.50 mm and an MIC of 0.31 ± 0.00 mg/mL. The in silico approach showed that all compounds detected in SFr and SF had high activity (between −5.368 and 8.416 kcal/mol) against the receptors studied, including NADPH oxidase, human acetylcholinesterase, and beta-ketoacyl-[acyl carrier protein] synthase.
1. Introduction
Medicinal plants serve as natural reservoirs of biologically active chemicals. Throughout history, people have discovered and used them for therapeutic or medicinal purposes [1]. According to the literature, almost 30% of plants are used for therapeutic purposes [2]. Medicinal plants contain various bioactive molecules, such as flavonoids, phenolic acids, tannins, carotenoids, sterols, and terpenoids [3]. These phytochemicals have shown promising microbiostatic and antimicrobial activities against a variety of pathogenic microorganisms [4,5,6]. Plants produce these compounds in response to pathogenic threats or stress conditions. Importantly, terpenoids, alkaloids, and polyphenols are involved in biological effects, including antioxidant, antibacterial, anticancer, and antidiabetic properties [7]. Due to their bioactive compounds—which are advantageous to human health against a variety of pathologies—as well as their industrial and agro-food applications, the use of medicinal plants has increased in recent years [8,9,10].
The family Solanaceae is a large angiosperm family with 96 genera and approximately 2300 species [11]. The genus Solanum is largely used as a drug source in medicines [12]. This genus is reported to contain steroids, saponins, alkaloids, terpenes, flavonoids, lignans, sterols, phenolic compounds, and coumarins [13]. Solanum spp. exhibit a wide range of pharmacological activities, including cytotoxicity against various tumors, such as colorectal, prostate, and breast cancers [14]. The species S. elaeagnifolium possesses anti-inflammatory, analgesic, antioxidant, and insecticidal activity, as well as hepatoprotective and anticancer activity [14,15]. Some of these biological activities may be due to its richness in quercetin, astragalin, and kaempferol 8-C-d-galactoside [4,13,14,16].
In the present work, the chemical constitution of hydroethanolic extracts from S. elaeagnifolium leaves and fruits was analyzed by use of HPLC-DAD as well as evaluating their antioxidant and antibacterial properties using in vitro and in silico studies.
2. Material and Methods
2.1. Plant Collection
S. elaeagnifolium (Figure 1) was gathered during the ripening stage (end of March 2022) in the city of Fez, Morocco (34°04′04.2 N, 5°01′26.4 W). Professor Amina Bari identified the plant under E17/1405.

Figure 1.
Photographs of S. elaeagnifolium; S. elaeagnifolium fruits (A) and S. elaeagnifolium aerial parts (B).
2.2. Preparation of Extract
Hydroethanolic extracts of the leaves and fruits of S. elaeagnifolium were prepared by maceration. In brief, 25 g of plant powder was mixed with 250 mL of ethanol (70%). The mixture was macerated for 24 h at room temperature. Finally, this mixture was filtered by use of Whatman paper. The obtained extracts were kept at 4 °C [17]. The extraction yield was calculated by the following formula:
where Y (%) is the yield of the extract, QE is the quantity of the extract, and QP is the quantity of the powder.
2.3. Total Polyphenols
The Folin–Ciocâlteu reagent (FCR) assay was used to determine the total phenolic content in the extract. In a test tube, 0.50 mL of the extract was combined with 2.5 mL of FCR (10-fold dilution). After shaking, 4 mL of Na2CO3 (7.5%) was poured into the mixture before being incubated for 30 min at 45 °C. A UV–visible spectrophotometer was used to read the absorbance at 765 nm against a blank. A calibration curve was plotted using gallic acid as a reference standard. The results are given in milligrams of gallic acid equivalents per gram of extract (mg AGE/g Ex) [18].
2.4. Flavonoids Content
The aluminum trichloride colorimetric assay was used to determine the flavonoid content in the extract. Briefly, 1 mL of each extract was added to 5 mL of distilled water before being mixed with 0.3 mL of 5% NaNO2. Next, after being mixed with 0.3 mL of 10% AlCl3, the mixture was left to stand for 5 min at room temperature. Subsequently, 2 mL of 1 M NaOH was added to the reaction medium before the total volume was made up to 10 mL with distilled water. The whole mixture was then incubated in the shade at ambient temperature for 30 min. Afterward, the absorbance was measured at a wavelength set to 510 nm against the control by use of a UV–visible spectrophotometer. The content of flavonoids was expressed as milligrams of quercetin equivalents per 1 g of extract (mg QE/g extract) [19].
2.5. HPLC-DAD Analysis
Hydroethanolic extracts from S. elaeagnifolium fruit and leaves were analyzed using reverse-phase high-performance liquid chromatography (HPLC). A Thermo Scientific HPLC system with an MOS-1 HYPERSIL 250 4.6 mm SS Exsil ODS 5 μm analytical column was used for analysis. The separation was carried out in gradient mode with two solvents—A (water) and C (acetonitrile)—according to the following elution gradient: 80% A, 20% C for 1 min; 60% A, 40% C for 2.5 min; and 80% A, 20% C for 4 min. The flow rate was 1 mL/min, and the injection volume was 5 μL. Notably, separation was performed at a constant temperature of 40 °C, and spectrophotometric detection was performed at 254, 280, 320, 350, and 540 nm. Compounds were identified by comparing their retention times and UV spectra with those of authentic standards [17].
2.6. Antioxidant Capacity
2.6.1. DPPH Test
Briefly, 50 μL test samples of the plant extract at various concentrations were mixed with 50 μL of a DPPH solution (0.2 mM in methanol). Next, by use of a UV–visible spectrophotometer, the absorbance was read at 517 nm after 30 min of incubation in the dark. The results are reported as a percentage of inhibition by use of the following equation [20]:
where AC is the uptake of the negative control, and AE is the uptake of the extract.
2.6.2. FRAP Test
In summary, 0.2 mL of the extract was combined with 0.50 mL of phosphate buffer and 0.5 mL of 1% K3[Fe(CN)6]. After 20 min of incubation at 50 °C, the mixture was acidified with 0.5 mL of 10% trichloroacetic acid (TCA). Subsequently, 0.5 mL of distilled water and 0.1 mL of FeCl3 (0.1%) were combined with 0.5 mL of supernatant. The absorbance was determined at 700 nm [13,21].
2.6.3. TAC Test
Antioxidant activity was measured by adding 1 mL of a reagent containing 0.6 M H2SO4, 28 mM Na2PO4, and 4 mM (NH4)2MoS4 to 100 μL of extract at various concentrations. The tubes were then tightly closed before being incubated for 90 min at 95 °C. At 695 nm, absorbance was measured after cooling. The negative control was 100 μL of methanol after 1 mL of the above reagent had been added. Under identical conditions, the samples and controls were incubated. The findings were reported in milligrams of ascorbic acid equivalents per gram (mg EAA/g) [22].
2.7. Antimicrobial Properties of Extracts of S. elaeagnifolium Leaves and Fruits
2.7.1. Antimicrobial Activity Examination
Both the leaf (SF) and fruit (SFr) extracts of S. elaeagnifolium were tested for antibacterial activity using the disk diffusion assay. In brief, bacteria and C. albicans were inoculated into Petri dishes with Mueller–Hinton (MH) and malt extract (ME) media, respectively. Next, decimal dilutions in sterile saline were made by use of fresh cultures previously grown in MH and ME media. The final inoculum was adjusted to be 106–108 CFU/m. Next, the Petri dishes were inoculated with bacteria, and fungi were treated with 15 µL of 100 mg/mL SFr and SF using six-millimeter-diameter disks. To compare the effectiveness of SFr and SF, conventional antibiotics such as ampicillin for bacterial strains and the antifungal fluconazole for C. albicans were utilized as positive and negative controls, respectively. Thereafter, Bacteria and C. albicans were cultured in Petri dishes and incubated at 37 °C. After 1 day post-inoculation for bacteria and 2 days post-inoculation for C. albicans, the inhibition diameters were determined [23].
2.7.2. Minimum Inhibitory Concentration (MIC) Determination
The MICs of SFr and SF against four bacteria and C.albicans were determined as previously described [23]. In summary, the microplaque was prepared in aseptic conditions; a volume of 100 μL of SFr and SF with a dilution of 1:5 (v/v) was pipetted into the first column of the plaque, before 50 μL of MH or ME was added. Next, serial dilutions were performed by use of two-fold dilution. After 1 day post-inoculation for bacteria and 2 days post-inoculation for C. albicans, MICs were determined by using the colorimetric method (TTC 0.2% (p/v)) [24,25].
2.8. In Silico Studies
Briefly, phytochemicals contained in the hydroethanolic extract of S. elaeagnifolium’s aerial parts were taken from the PubChem database in SDF format. Next, compounds were prepared for the docking process by use of the OPLS3 force field and the LigPrep tool of Schrödinger Software. After taking different ionization states into consideration, 32 stereoisomers were generated for each ligand (pH 7.0 2.0).
Notably, three-dimensional crystal configurations of NAD(P)H oxidase, human acetylcholinesterase, Escherichia coli receptor (eta-ketoacyl-acyl carrier protein) synthase, and Staphylococcus aureus nucleoside diphosphate kinase were taken from the Protein Data Bank in PDB format using the PDB IDs 2CDU, 4EY7, 1FJ4, and 3Q8U, respectively. Schrödinger-Maestro v11.5’s protein preparation wizard was used to generate and construct the structures. Selenomethionines were converted into methionines, all water was removed, and heavy atoms were given hydrogens. Charges and bond ordering were also assigned, while heavy atoms’ RMSD was adjusted to 0.30 using the OPLS3 force field. By clicking on any ligand atom, the receptor grid was immediately produced. The volumetric space used was 20 × 20 × 20. In the Glide package of Schrödinger-Maestro v. 11.5, the non-cis/trans amide bond was penalized during SP flexible ligand docking. The charge cutoff was fixed at 0.150, while the van der Waals scaling factor was set to 0.80. Energy-efficient postures served as the basis for the final scoring, which was represented by the Glide score. Notably, the best-docked location with the lowest Glide score value was noted [26].
2.9. Statistical Analysis
All values were presented as means ± SD of triplicate experimental studies. Analysis of variance was used to determine the mean significance of the independent variables. Tukey’s multiple comparison test at p < 0.05 was conducted by use of GraphPad Prism 8.0.1.
3. Results and Discussion
3.1. Analysis of the Chemical Composition of SF and SFr
The extraction of the two parts of the S. elaeagnifolium plant showed a difference in yields. Notably, the yield of fruits was 17.5%, while the yield of leaf extract was 11.6%. Importantly, multiple factors can influence the extraction yield, including the maceration time, harvest time, drying time, extraction solvent, and plant part used [13,27,28,29]. The extraction yield of the leaf was comparable to the value discovered by Bouslamti et al., who reported a yield of 10.2% for the hydroethanolic extract of the leaves. Feki et al. reported that the yield of the methanolic extract of S. elaeagnifolium seeds was 7.7% [30].
Table 1 shows the findings of the polyphenol and flavonoid evaluations. The phenolic content of the fruit extract was 0.1530 ± 0.001 mg EAG/g, while that of the leaf extract was 0.11 ± 0.01 mg EAG/g. The flavonoid content of the fruit extract was 0.015 ± 0.001 mg EQ/g, while that of the leaf extract was 0.0040 ± 0.00020 mg EQ/g. These findings are comparable to those of Bouslamti et al. [13], who discovered that the polyphenol content of the genus Solanum was 1.580 ± 0.030 mg EAG/g for hydroacetonic extract and 2.540 ± 0400 mg EAG/g for hydroethanolic extract. Researchers in Tunisia discovered various concentrations of polyphenols and flavonoids depending on the extraction solvent and the stages of fruit ripening [31].

Table 1.
Contents of phytochemical compounds in S. elaeagnifolium extract.
Polyphenols and flavonoids are the most bioactive secondary metabolites in plants. This chemical class may vary in terms of concentrations depending on the plant, the plant part used, the extraction method, the life cycle, and the extraction solvent used [32,33]. HPLC/DAD profile analysis of two extracts of S. elaeagnifolium identified four polyphenolic compounds, namely, luteolin, quercetin, gallic acid, and naringenin (Table 2; Figure 2). These findings are consistent with those reported by Al-Hamaideh and co-authors [14], who discovered that the genus Solanum contains phenols such as luteolin and apigenin. Notably, soil, climatic conditions, relative humidity, and postharvest treatments (e.g., drying, harvesting, and extraction) can influence phenol content variation in plants [34].

Table 2.
Chromatographic analysis of phenolic compounds detected in hydroethanolic extracts of the leaves and fruit of S. elaeagnifolium by HPLC.

Figure 2.
HPLC-DAD chromatogram of Solanum elaeagnifolium hydroethanolic extracts at 280 nm (leaves (A) and fruit (B)) and standards (C) (luteolin (1), quercetin (2), gallic acid (3), and naringenin (4)).
3.2. Antioxidant Activity
The DPPH method was used to determine the radical scavenging activity of S. elaeagnifolium extracts, based on the measurement of the extracts’ DPPH free radical scavenging capacity. Figure 3A shows the absorbance as a function of various concentrations of SF and SFr, while Figure 3B depicts the median inhibitory concentration (IC50). The IC50 of the fruit and leaf extracts was 35.15 ± 6.09 μg/mL and 132.46 ± 11.73 μg/mL, respectively. This activity may have been due to the presence of polyphenols and flavonoids [35,36].

Figure 3.
Antioxidant capacity assessed by the DPPH method: dose–effect curves (A) and IC50 (B). Antioxidant power assessed by the FRAP method (C) and EC50 (D). Total antioxidant capacity assessed by the phosphomolybdate method (E).
The FRAP test results showed that both S. elaeagnifolium extracts had considerable reducing activity depending on the plant part utilized; notably, SF and SFr had EC50 values of 83.46 ± 7.69 μg/mL and 462.36 ± 10.43 μg/mL, respectively (Figure 3 C,D). The HPLC results showed the existence of phenolic compounds with a hydroxyl group with the ability to reduce iron, such as luteolin, kaempferol, apigenin, and quercetin [37,38].
The results showed that SFr had the highest total antioxidant activity of 939.66 ± 5.01 μgAAE/mg, followed by SF, which scored 890.10 ± 7.76 μg AAE/mg (3E). The antioxidant potential of the fruit and leaf extracts was found to be greater than that of quercetin. Many studies have confirmed that the genus Solanum has a high total antioxidant activity; notably, Bouslamti et al., who worked on the leaves of this invasive plant, discovered an antioxidant capacity of 2.54 ± 0.40 mg EAG/g for the hydroethanolic extract [13]. Rajalakshmi and Pugalenthi found that the ethanolic extract of S. elaeagnifolium possessed a total antioxidant activity of 19.40 mg/mL [39].
3.3. Antimicrobial Activity
The inhibitory zone diameters and MICs of SFr and SF against the tested bacterial strains and C. albicans are shown in Figure 4 and Table 3 and Table 4. In comparison to the antibiotic ampicillin, SFr and SF showed intriguing antibacterial activity; notably, SFr showed the highest inhibitory effect vs. B. subtilis, with an inhibition diameter of 10. 670 ± 0.570 mm and an MIC of 2.50 ± 0.0 mg/mL, while SF showed strong activity versus E. coli K12, with an inhibition diameter of 12.33 ± 0.57 mm and an MIC of 2.50 ± 0 mg/mL. Importantly, SFr showed a potent antibacterial effect versus Gram (+) bacteria, while SF showed good antibacterial activity against Gram (−) bacteria. The results showed that the SFr extract of S. elaeagnifolium possessed antifungal activity versus C. albicans, with an inhibition diameter of 9.00 ± 0.500 mm and an MIC of 0.31 ± 0 mg/mL.

Figure 4.
Photographs of the antimicrobial activity of S. elaeagnifolium leaf and fruit extracts.

Table 3.
Antimicrobial properties of S. elaeagnifolium leaf and fruit extracts.

Table 4.
MICs of S. elaeagnifolium leaf and fruit extracts’ antimicrobial activity (mg/mL).
Our results are consistent with those of Bouslamti and co-authors, who discovered the antibacterial activity of hydroethanolic and hydroacetonic extracts against bacteria including E. coli K12, S. aureus ATCC 6633, B. subtilis DSM 6333, and Proteus mirabilis ATCC 29,906 [13]. Extracts of the genus Solanum demonstrated good antibacterial effects against some clinically important pathogenic bacteria, including Staphylococcus lentus and Staphylococcus haemolyticus [40]. The chemical composition of S. elaeagnifolium leaf and fruit extracts is rich in secondary metabolites such as quercetin, chlorogenic acid, and apigenin [14], which contribute to its antimicrobial activity. These molecules are recognized for their bioactivity, as they possess hydroxyl groups or phenolic rings. Notably, phenolic compounds have the ability to bind to proteins and the bacterial membrane to form complexes [41].
Species of the Solanum genus possess antimicrobial activity, e.g., Solanum surattense has shown antibacterial activity against pathogenic strains—particularly salmonella typhi and Shigella dysenteriae [42,43]. The antibacterial activity observed in Solanaceae is usually related to chemicals such as terpenoids, alkaloids, and tannins that can break through the bacterial wall or the plasma membrane and exert bactericidal or bacteriostatic effects [43,44].
3.4. In Silico Studies
The phytocompounds identified in the hydroethanolic extracts of S. elaeagnifolium showed important activity. Regarding antioxidant activity, gallic acid, luteolin, quercetin, and naringenin presented Glide scores of −6.561, −6.328, −6.23, and −5.712 Kcal/mol, respectively, in the active site of NADPH oxidase. These compounds also presented Glide scores of −6.271, −8.416, −8.173, and −8.244 Kcal/mol, respectively, in the active site of human acetylcholinesterase. Regarding antimicrobial activity, gallic acid, luteolin, quercetin, and naringenin showed Glide scores of −6.756, −6.503, −5.912, and −6.703 kcal/mol, respectively, in the active site of E. coli beta-ketoacyl-[acyl carrier protein] synthase. Furthermore, they presented Glide scores of −5.368, −6.145, −5.95, and −6.477 Kcal/mol, respectively, in the active site of Staphylococcus aureus nucleoside diphosphate kinase (Table 5).

Table 5.
Docking results with ligands in NAD(P)H Oxidase, human acetylcholinesterase, E. coli beta-ketoacyl-[acyl carrier protein] synthase, and Staphylococcus aureus nucleoside diphosphate kinase receptors.
Figure 5 and Figure 6 show the number and nature of possible bonds between the ligands in the active sites. In the NADPH oxidase receptor, gallic acid established four hydrogen bonds with residues TYR 188, LYS 187, CYS 242, and ILE 160, and one salt bridge with LYS187. In human acetylcholinesterase, luteolin established one hydrogen bond with residue PHE 295 and two Pi–Pi stacking bonds with residues TRP 286 and TYR 341. Concerning the antimicrobial activity, gallic acid established four hydrogen bonds with residues THR 300, THR 302, HIE 298, and HIE 333, and one Pi–Pi stacking bond with residue PHE 392 in the active site of E. coli beta-ketoacyl-[acyl carrier protein] synthase. Moreover, naringenin established two hydrogen bonds with residues ARG 111 and LYS 9.

Figure 5.
Two-dimensional (2D) view of ligands’ interaction with active sites: (A) interactions between gallic acid and the 2CDU active site; (B) interactions between luteolin and the 4EY7 active site; (C) interactions between the active site of 1FJ4 and gallic acid; (D) interactions between the active site of 3Q8U and naringenin.

Figure 6.
Three-dimensional (3D) view of ligands’ interaction with active sites: (A) interactions between gallic acid and the 2CDU active site; (B) interactions between luteolin and the 4EY7 active site; (C) interactions between the active site of 1FJ4 and gallic acid; (D) interactions between the active site of 3Q8U and naringenin.
4. Conclusions
S. elaeagnifolium leaf and fruit extracts were found to have antioxidant and antibacterial properties against clinical-drug-resistant bacteria in this study. Chemical analysis of S. elaeagnifolium extracts demonstrated the existence of four compounds—namely, gallic acid, quercetin, luteolin, and naringenin—that may be responsible for the observed activities. Fruit and leaf extracts of S. elaeagnifolium may be useful to help control antibacterial resistance phenomena and free-radical-related issues; however, potential adverse effects on non-target organisms need to be assessed before any use.
Author Contributions
All authors contributed to the writing—original draft, formal analysis, review and editing, data curation, and funding acquisition. All authors have read and agreed to the published version of the manuscript.
Funding
This work was funded by the Researchers Supporting Project number (RSP-2022R437), King Saud University, Riyadh, Saudi Arabia, and the authors would like to extend their appreciation for their support.
Institutional Review Board Statement
Not applicable.
Informed Consent Statement
Not applicable.
Data Availability Statement
Not applicable.
Acknowledgments
This work was funded by the Researchers Supporting Project number (RSP-2022R437), King Saud University, Riyadh, Saudi Arabia, and the authors would like to extend their appreciation for their support.
Conflicts of Interest
The authors declare no conflict of interest.
Sample Availability
Samples of the compounds are not available from the authors.
References
- Egamberdieva, D.; Mamedov, N.; Ovidi, E.; Tiezzi, A.; Craker, L. Phytochemical and Pharmacological Properties of Medicinal Plants from Uzbekistan: A Review. J. Med. Act. Plants 2017, 5, 59–75. [Google Scholar] [CrossRef]
- Kumar, M.; Prakash, S.; Radha; Kumari, N.; Pundir, A.; Punia, S.; Saurabh, V.; Choudhary, P.; Changan, S.; Dhumal, S.; et al. Beneficial Role of Antioxidant Secondary Metabolites from Medicinal Plants in Maintaining Oral Health. Antioxidants 2021, 10, 1061. [Google Scholar] [CrossRef] [PubMed]
- Berrougui, H.; Isabelle, M.; Cherki, M.; Khalil, A. Marrubium vulgare Extract Inhibits Human-LDL Oxidation and Enhances HDL-Mediated Cholesterol Efflux in THP-1 Macrophage. Life Sci. 2007, 80, 105–112. [Google Scholar] [CrossRef] [PubMed]
- Enwa, F. A Review on the Phytochemical Profile and the Antibacterial Susceptibility Pattern of Some Clinical Isolates to the Ethanolic Leaves Extract of Moringa Oleifera LAM (Moringaceae). Int. J. Adv. Res. 2013, 1, 226–238. [Google Scholar]
- Kara, M.; Assouguem, A.; Abdou R., Z.; Bahhou, J. Phytochemical Content and Antioxidant Activity of Vinegar Prepared from Four Apple Varieties by Different Methods. Trop. J. Nat. Prod. Res. 2021, 5, 1578–1585. [Google Scholar] [CrossRef]
- Ullah, M.; Mehmood, S.; Khan, R.A.; Ali, M.; Fozia, F.; Waqas, M.; Ullah, R.; Alotaibi, A.; Sultan, M.A. Sultan Assessment of Antidiabetic Potential and Phytochemical Profiling of Viscum Album, a Traditional Antidiabetic Plant. J. Food Qual. 2022, 2022, 5691379. [Google Scholar] [CrossRef]
- Ben Khadher, T.; Aydi, S.; Mars, M.; Bouajila, J. Study on the Chemical Composition and the Biological Activities of Vitis Vinifera Stem Extracts. Molecules 2022, 27, 3109. [Google Scholar] [CrossRef]
- Leal, C.; Santos, R.; Pinto, R.; Queiroz, M.; Rodrigues, M.; Saavedra, M.; Barros, A.; Gouvinhas, I. Recovery of Bioactive Compounds from White Grape (Vitis Vinifera L.) Stems as Potential Antimicrobial Agents for Human Health. Saudi J. Biol. Sci. 2020, 27, 1009–1015. [Google Scholar] [CrossRef]
- Sarker, U.; Oba, S.; Ercisli, S.; Assouguem, A.; Alotaibi, A.; Ullah, R. Bioactive Phytochemicals and Quenching Activity of Radicals in Selected Drought-Resistant Amaranthus Tricolor Vegetable Amaranth. Antioxidants 2022, 11, 578. [Google Scholar] [CrossRef]
- Ullah, R.; Alqahtani, A.S. GC-MS Analysis, Heavy Metals, Biological, and Toxicological Evaluation of Reseda muricata and Marrubium vulgare Methanol Extracts. Evid.-Based Complement. Altern. Med. 2022, 2022, 2284328. [Google Scholar] [CrossRef]
- Manoko, M.L.K.; van Weerden, G.M.; van Berg, R.G.; Mariani, C. A New Tetraploid Species of Solanum L. Sect. Solanum (Solanaceae) from Tanzania. PhytoKeys 2012, 16, 65–74. [Google Scholar] [CrossRef][Green Version]
- El-Shaboury, G.A.; Al-Wadi, H.M.; Badr, A. Biodiversity of Some Solanum Species from Southwestern Saudi Arabia’s Highlands. Bot. Lett. 2021, 168, 246–255. [Google Scholar] [CrossRef]
- Bouslamti, M.; El Barnossi, A.; Kara, M.; Alotaibi, B.; Kamaly, O.; Assouguem, A.; Badiaa, L.; Benjelloun, A. Total Polyphenols Content, Antioxidant and Antimicrobial Activities of Leaves of Solanum elaeagnifolium Cav. from Morocco. Molecules 2022, 27, 4322. [Google Scholar] [CrossRef] [PubMed]
- Al-hamaideh, K.; Dmour, I.; El-Elimat, T.; Afifi, F. UPLC-MS Profile and Anti-Proliferative Activity of the Berries of an Aggressive Wild-Growing Weed: Solanum elaeagnifolium Cav. (Solanaceae). Trop. J. Nat. Prod. Res. 2020, 4, 1131–1138. [Google Scholar] [CrossRef]
- Badawy, A.; Zayed, R.; Ahmed, S.; Hassanean, H. Phytochemical and Pharmacological Studies of Solanum elaeagnifolium Growing in Egypt. J. Nat. Prod. 2013, 6, 156–167. [Google Scholar]
- Hawas, U.W.; Soliman, G.M.; El-Kassem, L.T.A.; Farrag, A.R.H.; Mahmoud, K.; León, F. A New Flavonoid C-Glycoside from Solanum elaeagnifolium with Hepatoprotective and Curative Activities against Paracetamol-Induced Liver Injury in Mice. Z. Für Nat. C 2013, 68, 19–28. [Google Scholar]
- Mssillou, I.; Agour, A.; Slighoua, M.; Chebaibi, M.; Amrati, F.E.-Z.; Alshawwa, S.; Kamaly, O.; El Moussaoui, A.; Badiaa, L.; Derwich, E. Ointment-Based Combination of Dittrichia viscosa L. and Marrubium vulgare L. Accelerate Burn Wound Healing. Pharmaceuticals 2022, 15, 14. [Google Scholar] [CrossRef]
- Li, H.-B.; Cheng, K.-W.; Wong, C.-C.; Fan, K.-W.; Chen, F.; Jiang, Y. Evaluation of Antioxidant Capacity and Total Phenolic Content of Different Fractions of Selected Microalgae. Food Chem. 2007, 102, 771–776. [Google Scholar] [CrossRef]
- Quettier-Deleu, C.; Gressier, B.; Vasseur, J.; Dine, T.; Brunet, C.; Luyckx, M.; Cazin, M.; Cazin, J.C.; Bailleul, F.; Trotin, F. Phenolic Compounds and Antioxidant Activities of Buckwheat (Fagopyrum esculentum Moench) Hulls and Flour. J. Ethnopharmacol. 2000, 72, 35–42. [Google Scholar] [CrossRef]
- Gandhiappan, J.; Rengasamy, R. Comparative Study on Antioxidant Activity of Different Species of Solanaceae Family. Adv. Appl. Sci. Res. 2012, 3, 1538–1544. [Google Scholar]
- Abdelfattah, E.M.; Aimad, A.; Bourhia, M.; Chebbac, K.; Salamatullah, A.M.; Soufan, W.; Nafidi, H.-A.; Aboul-Soud, M.A.M.; Ouahmane, L.; Bari, A. Insecticidal and Antifungal Activities of Chemically-Characterized Essential Oils from the Leaves of Withania frutescens L. Life 2022, 12, 88. [Google Scholar] [CrossRef]
- Koncić, M.Z.; Kremer, D.; Karlović, K.; Kosalec, I. Evaluation of Antioxidant Activities and Phenolic Content of Berberis Vulgaris L. and Berberis Croatica Horvat. Food Chem. Toxicol. 2010, 48, 2176–2180. [Google Scholar] [CrossRef]
- Lafraxo, S.; El Barnossi, A.; El Moussaoui, A.; Bourhia, M.; Salamatullah, A.M.; Alzahrani, A.; Akka, A.A.; Choubbane, A.; Akhazzane, M.; Aboul-soud, M.A.M.; et al. Essential Oils from Leaves of Juniperus thurifera L., Exhibiting Antioxidant, Antifungal and Antibacterial Activities against Antibiotic-Resistant Microbes. Horticulturae 2022, 8, 321. [Google Scholar] [CrossRef]
- Chebbac, K.; Ghneim, H.K.; El Moussaoui, A.; Bourhia, M.; El Barnossi, A.; Ouaritini, Z.B.; Salamatullah, A.M.; Alzahrani, A.; Aboul-soud, M.A.M.; Giesy, J.P.; et al. Antioxidant and Antimicrobial Activities of Chemically-Characterized Essential Oil from Artemisia aragonensis Lam. against Drug-Resistant Microbes. Molecules 2022, 27, 1136. [Google Scholar] [CrossRef] [PubMed]
- Sarker, S.D.; Nahar, L.; Kumarasamy, Y. Microtitre Plate-Based Antibacterial Assay Incorporating Resazurin as an Indicator of Cell Growth, and Its Application in the in Vitro Antibacterial Screening of Phytochemicals. Methods 2007, 42, 321–324. [Google Scholar] [CrossRef] [PubMed]
- Beniaich, G.; Hafsa, O.; Maliki, I.; Bin Jardan, Y.A.; El Moussaoui, A.; Chebaibi, M.; Agour, A.; Zouirech, O.; Nafidi, H.-A.; Khallouki, F. GC-MS Characterization, In Vitro Antioxidant, Antimicrobial, and In Silico NADPH Oxidase Inhibition Studies of Anvillea Radiata Essential Oils. Horticulturae 2022, 8, 886. [Google Scholar] [CrossRef]
- Rezouki, S.; Allali, A.; Bouchra, L.; Eloutassi, N.; Fadli, M. The Impact of the Harvesting Period and Drying Conditions on the Essential Oil Yield of Rosmarinus Officinalis, Thymus Satureioides and Origanum Compactum from the Taza-Taounate Region. Asian J. Agric. Biol. 2021, 2021, 202004251. [Google Scholar] [CrossRef]
- El Moussaoui, A.; Zahra, J.F.; Almehdi, A.; Elmsellem, H.; Benbrahim, K.F.; Bari, A. Antibacterial, Antifungal and Antioxidant Activity of Total Polyphenols of Withania frutescens L. Bioorganic Chem. 2019, 93, 103337. [Google Scholar] [CrossRef]
- Jeyaraj, E.J.; Lim, Y.Y.; Choo, W.S. Effect of Organic Solvents and Water Extraction on the Phytochemical Profile and Antioxidant Activity of Clitoria ternatea Flowers. ACS Food Sci. Technol. 2021, 1, 1567–1577. [Google Scholar] [CrossRef]
- Feki, H.; Koubaa, I.; Damak, M. Secondary Metabolites and Antioxidant Activity of Seed Extracts from Solanum elaeagnifolium Cav. Mediterr. J. Chem. 2014, 2, 639–647. [Google Scholar] [CrossRef]
- Houda, M.; Derbré, S.; Jedy, A.; Tlili, N.; Legault, J.; Richomme, P.; Limam, F.; Saidani-Tounsi, M. Combined Anti-AGEs and Antioxidant Activities of Different Solvent Extracts of Solanum elaeagnifolium Cav (Solanacea) Fruits during Ripening and Related to Their Phytochemical Compositions. EXCLI J. 2014, 13, 1029–1042. [Google Scholar] [CrossRef]
- McGhie, T.K.; Hunt, M.; Barnett, L.E. Cultivar and Growing Region Determine the Antioxidant Polyphenolic Concentration and Composition of Apples Grown in New Zealand. J. Agric. Food Chem. 2005, 53, 3065–3070. [Google Scholar] [CrossRef]
- Kara, M.; Assouguem, A.; Benmessaoud, S.; El Fadili, M.; Alshawwa, S.; Kamaly, O.; Saghrouchni, H.; Zerhouni, R.; Bahhou, J. Contribution to the Evaluation of Physicochemical Properties, Total Phenolic Content, Antioxidant Potential, and Antimicrobial Activity of Vinegar Commercialized in Morocco. Molecules 2022, 27, 770. [Google Scholar] [CrossRef]
- Moussaoui, A.E.; Bourhia, M.; Jawhari, F.Z.; Khalis, H.; Chedadi, M.; Agour, A.; Salamatullah, A.M.; Alzahrani, A.; Alyahya, H.K.; Alotaibi, A.; et al. Responses of Withania frutescens (L.) Pauquy (Solanaceae) Growing in the Mediterranean Area to Changes in the Environmental Conditions: An Approach of Adaptation. Front. Ecol. Evol. 2021, 9, 666005. [Google Scholar] [CrossRef]
- Alonso, Á.; Castro-Mejías, R.; Rodrı́guez, M.C.; Guillén, D.; Barroso, C. Study of the Antioxidant Power of Brandies and Vinegars Derived from Sherry Wines and Correlation with Their Content in Polyphenols. Food Res. Int. 2004, 37, 715–721. [Google Scholar] [CrossRef]
- Khiya, Z.; Oualcadi, Y.; Gamar, A.; Berrekhis, F.; Zair, T.; Hilali, F.E. Correlation of Total Polyphenolic Content with Antioxidant Activity of Hydromethanolic Extract and Their Fractions of the Salvia Officinalis Leaves from Different Regions of Morocco. J. Chem. 2021, 2021, e8585313. [Google Scholar] [CrossRef]
- Pinheiro, R.G.R.; Pinheiro, M.; Neves, A.R. Nanotechnology Innovations to Enhance the Therapeutic Efficacy of Quercetin. Nanomaterials 2021, 11, 2658. [Google Scholar] [CrossRef]
- Tian, C.; Liu, X.; Chang, Y.; Wang, R.; Lv, T.; Cui, C.; Liu, M. Investigation of the Anti-Inflammatory and Antioxidant Activities of Luteolin, Kaempferol, Apigenin and Quercetin. S. Afr. J. Bot. 2021, 137, 257–264. [Google Scholar] [CrossRef]
- Rajalakshmi, P.; Pugalenthi, M. Phytochemical Screening and In Vitro Antioxidant Activity of Lantana camara L. and Solanum elaeagnifolium C. Int. J. Bot. Stud. 2016, 1, 26–29. [Google Scholar]
- Balavivekananthan, S.; Xavier, T.; Kumar, S.; Sabitha, R. Antibacterial Activity of Solanum elaeagnifolium Cav. Stem and Leaf Extract against Human Pathogenic Bacteria. Res. J. Pharm. Technol. 2021, 14, 1339–1345. [Google Scholar] [CrossRef]
- Nitiema, L.; Savadogo, A.; Simpore, J.; Dianou, D.; Traore, A. In Vitro Antimicrobial Activity of Some Phenolic Compounds (Coumarin and Quercetin) Against Gastroenteritis Bacterial Strains. Int. J. Microbiol. Res. 2012, 3, 183–187. [Google Scholar]
- Kumar, P. A Review on the Pharmaceutical Activity of Solanum Surattense. GSC Adv. Res. Rev. 2021, 7, 038–044. [Google Scholar] [CrossRef]
- Gębarowska, E.; Łyczko, J.; Rdzanek, M.; Wiatrak, B.; Pląskowska, E.; Gołębiowska, H.; Kuźniarski, A.; Gębarowski, T. Evaluation of Antimicrobial and Chemopreventive Properties and Phytochemical Analysis of Solanum nigrum L. Aerial Parts and Root Extracts. Appl. Sci. 2022, 12, 6845. [Google Scholar] [CrossRef]
- Lu, M.; Li, T.; Wan, J.; Li, X.; Yuan, L.; Sun, S. Antifungal Effects of Phytocompounds on Candida Species Alone and in Combination with Fluconazole. Int. J. Antimicrob. Agents 2017, 49, 125–136. [Google Scholar] [CrossRef]
Publisher’s Note: MDPI stays neutral with regard to jurisdictional claims in published maps and institutional affiliations. |
© 2022 by the authors. Licensee MDPI, Basel, Switzerland. This article is an open access article distributed under the terms and conditions of the Creative Commons Attribution (CC BY) license (https://creativecommons.org/licenses/by/4.0/).